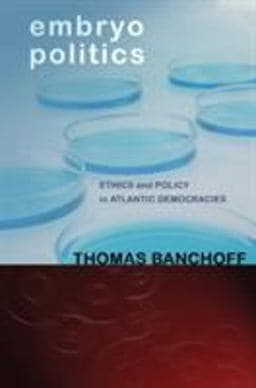
9780801460593

Out of Stock
Overview
A comprehensive overview of political struggles about embryo research over four decades in four countries.
| ISBN-13 | 9780801460593 |
|---|---|
| ISBN-10 | 080146059X |
| List Price | $130.00 |
| Format | - |
|---|---|
| Language | English |
| Pages | 304 pages |
| Publisher | Cornell University Press |
| Published On | 2011-05-15 |
View All Offers
Sort by:
Price

